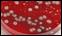

Estimated read time: 3-4 minutes
This archived news story is available only for your personal, non-commercial use. Information in the story may be outdated or superseded by additional information. Reading or replaying the story in its archived form does not constitute a republication of the story.
SALT LAKE CITY — Just about every parent is familiar with "the 5 second rule." If you drop food on the floor, the rule says it's OK to pick it up and eat it as long as it hasn't been there longer than 5 seconds. No big deal right? Or is it?
"If they drop a plate of apples, I don't want to cut a whole new apple. I'll just give it back to them," Utah mom Katie Hydrick said.
Everybody knows it's the 5 second rule, and Hydrick says most of her friends abide by it as well. "If they just dropped it, I think, 'How much dirt could really be on it?'" she said.
If they just dropped it, I think, 'How much dirt could really be on it?'
–Katie Hydrick, Utah mom
KSL News wanted to know too, so we took pacifiers and crackers — two common culprits that go floor to mouth — and tested them on the kitchen floor of Hydrick's home. Sample after sample spent exactly 5 seconds on the floor.
Next, we headed outside to the driveway and went through the same process, as fresh pacifiers and crackers hit the ground.
We also tried a spot away from the home — a place where you have little control over the cleanliness. We head to a busy diner at lunch hour and tested the 5 second rule there. But this time we place our pacifiers under the tables and our crackers in a walkway
When some of the people eating lunch wondered what on earth we were doing, we asked their reactions to the 5 second rule.
Driveway: Heavy amounts of bacteria, yeast and mold.
Public diner: Light amounts of bacteria, yeast and mold.
"Oh, there is no way! The floor is filthy. I would never do that," one man said.
"I think as long as I pick it up and there are no hairs on it, it's good," a woman told us.
"Well, I would be torn," another woman said. "My dad told me never to waste food, but you just never know what's on the ground."
To find out what is on the ground, and what happens in those 5 seconds, we took our samples to Richards Laboratories in Pleasant Grove for testing.
"The kitchen was definitely the cleanest," said Daniel O'Brien, technical director at Richards Laboratories.
The crackers dropped on the kitchen floor showed light to moderate amounts of bacteria. The pacifiers showed light amounts of bacteria, along with yeast and mold.
On the outside pavement, however, we found more than just bacteria. Heavy amounts of mold and yeast were present on both items.
5 seconds, 1 second, it's all the same. As long as bacteria is concerned, it's all the same.
–Daniel O'Brien, Richards Laboratories
And what about our busy diner? There, O'Brien's team found light amounts of bacteria growth on all our samples, and a light amount of yeast and mold on just one of our samples.
None of our samples tested positive for serious things like salmonella or strep. In fact, most of what measured was common bacteria — but that could still pose a threat to children.
"Even really common bacteria can make you sick if it catches you in the right condition," O'Brien said.
But the most interesting finding essentially undermines the premise of the 5 second rule: "5 seconds, 1 second, it's all the same. As long as bacteria is concerned, it's all the same," O'Brien said.
So, while none of our samples contained anything more than common germs, the bottom line is time doesn't matter to bacteria. If you wouldn't feed it to your kids something that's been on the floor for 5 minutes or more, you probably shouldn't go with the 5 second rule either.
Email: dwimmer@ksl.com








